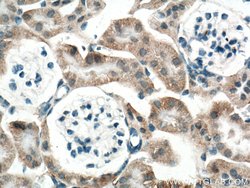
SLC25A39 Rabbit anti-Human, Mouse, Polyclonal, ProteinTech 150 &mu;L; Unconjugated:Antibodies,

missing translation for 'onlineSavingsMsg'
Learn More
Learn More
SLC25A39 Rabbit anti-Human, Mouse, Polyclonal, ProteinTech
Rabbit Polyclonal Antibody
Brand: Proteintech 14963-1-AP-150UL
This item is not returnable.
View return policy
Description
Aliquoting is unnecessary for -20°C storage.
SLC25A39 Polyclonal antibody specifically detects SLC25A39 in Human, Mouse samples. It is validated for Immunohistochemistry (Paraffin), Western BlotSpecifications
| SLC25A39 | |
| Polyclonal | |
| Unconjugated | |
| SLC25A39 | |
| 3010027G13Rik; CGI69; CGI-69; D11Ertd333e; hypothetical protein MGC63736; PRO2163; RGD1306193; Slc25a39; Solute carrier family 25 member 39; solute carrier family 25, member 39; zgc:63736 | |
| Rabbit | |
| Antigen affinity chromatography | |
| RUO | |
| 51629, 68066 | |
| -20°C | |
| Liquid |
| Immunohistochemistry (Paraffin), Western Blot | |
| 673 μg/mL | |
| PBS with 50% glycerol and 0.02% sodium azide | |
| Q9BZJ4, Q9D8K8 | |
| SLC25A39 | |
| SLC25A39 Fusion Protein Ag6825 | |
| 150 μL | |
| Primary | |
| Human, Mouse | |
| Antibody | |
| IgG |
Product Content Correction
Your input is important to us. Please complete this form to provide feedback related to the content on this product.
Product Title
Spot an opportunity for improvement?Share a Content Correction